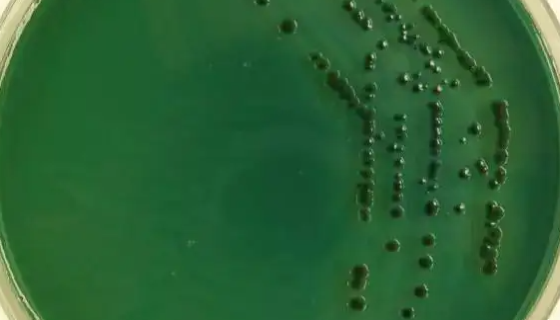
副溶血弧菌的菌株性质与生存环境及检测方法！
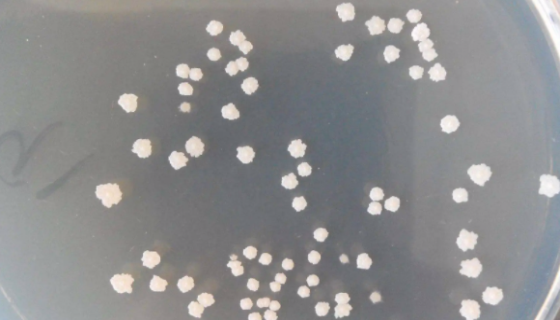
解淀粉芽孢杆菌的作用与功效及在农业中的应用！
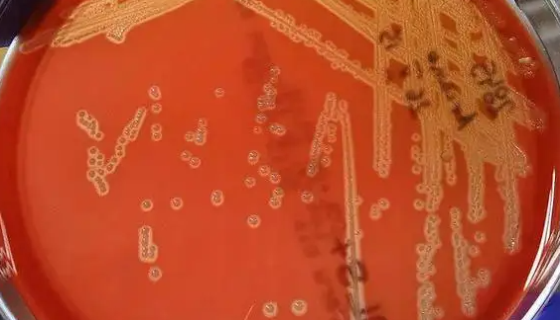
ATCC 55618 产琥珀酸放线杆菌的培养方法与实验内容！

腐皮镰孢的培养条件与实验内容及打管说明!
腐皮镰孢(拉丁纲名: Fungi Imperficti)是一...

BHK-21(仓鼠肾细胞)的培养步骤与应用!
BHK-21细胞是由IA-Macpherson和M-G.P-...
副溶血弧菌的菌株性质与生存环境及检测方法!
副溶血弧菌,是一种嗜盐性的革兰氏阴性菌,可以发酵葡萄糖,不产...

用于生产发酵泡菜的:肠膜明串珠菌肠膜亚种
肠膜明串珠菌肠膜亚种是肠膜明串珠菌肠膜亚种经接种、发酵培养、...
解淀粉芽孢杆菌的作用与功效及在农业中的应用!
解淀粉芽孢杆菌属于芽孢杆菌属,是一种具有广谱抑菌活性的细菌,...

人海马神经元细胞HPPNCs验收注意事项及培养步骤!
人海马神经元细胞HPPNCs,仅用于科学研究或者工业应用等非...

ATCC 19250 蟾分枝杆菌的培养条件与注意事项!
蟾蜍分枝杆菌是分枝杆菌科,长至丝状杆菌。蛋培养基上稀释接种,...

口腔链球菌的形态特征与主要价值及注意事项!
口腔链球菌是Streptococcus属的微生物,原产地为中...
ATCC 55618 产琥珀酸放线杆菌的培养方法与实验内容!
产琥珀酸放线杆菌,菌体杆状或球杆状,生长迅速时会产生短链。菌...